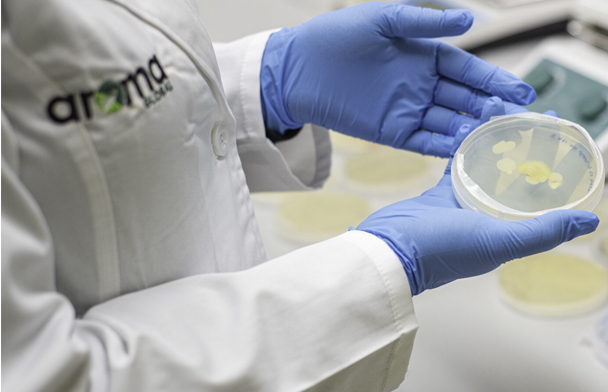

Aroma Global® transforma tus desafíos en soluciones innovadoras.
Te ofrecemos productos y servicios con respaldo científico, diseñados para garantizar resultados confiables.
Creamos juntos un plan de trabajo adaptado a tus necesidades y prioridades. Además, te ayudamos a obtener financiamiento para proyectos de I+D.
Vive la experiencia de trabajar con un equipo consolidado para impulsar tu negocio.
Impulsa tus ideas con proyectos de investigación y desarrollo hechos a la medida. Te ayudamos a postular y adjudicar fondos concursables, diseñando propuestas sólidas y ejecutables que maximizan el éxito de tu inversión en innovación.
Te ofrecemos un equipo científico especializado, laboratorios equipados y experiencia comprobada para llevar adelante tus iniciativas, desde la validación inicial hasta la obtención de resultados transferibles al mercado.
Te entregamos información microbiológica precisa y aplicable a tus proyectos.
Aroma Lab® (Melipilla) nace para responder la creciente demanda de servicios especializados en Bioinsumos y Fitopatología, entregando conocimiento científico de alto nivel para potenciar el crecimiento de cultivos vegetales y preservar su sanidad. Generando soluciones reales y competitivas a nuestros clientes.